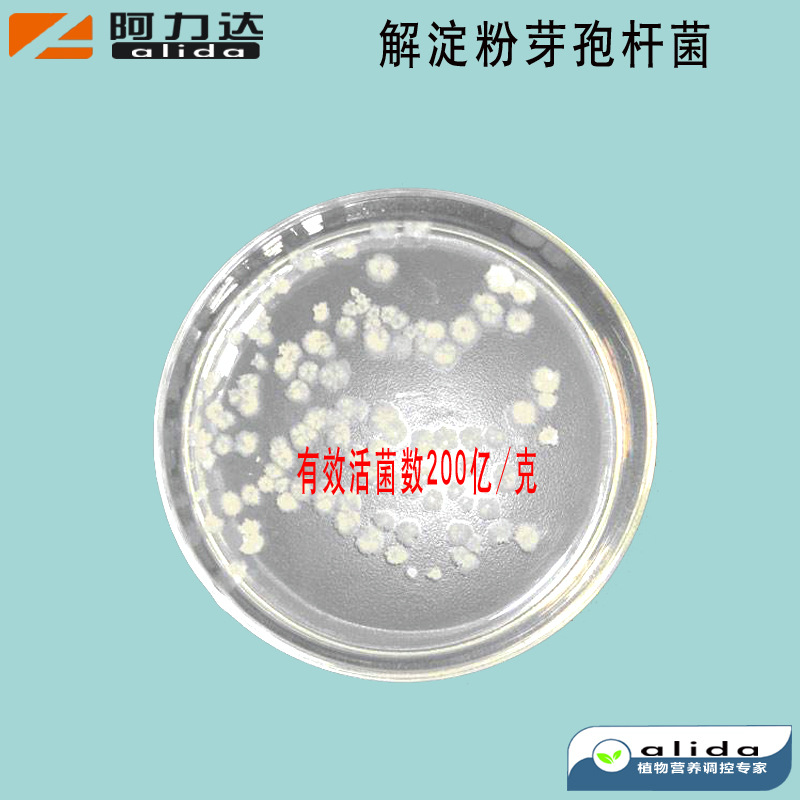

1688工业品为您提供在线免费查询更多化肥详细参数、实时报价、规格一览表。更多关于化肥多少钱一吨/化肥报价明细/化肥规格型号价格表/化肥批发市场价格/化肥官方报价等咨询,尽在1688工业品。询底价>
为你找到生物肥料相关产品

样品 广西生化黄腐酸钾水溶肥水产养殖 农业冲施肥糖蜜粉黄腐酸钾
山东济南
在线询价

腐植酸钠片状粉末农业级水产用腐植酸饲料级 腐植酸钠
山东济南
在线询价

硫酸锌 厂家直销硫酸锌 一水硫酸锌 七水硫酸质优价廉 现货批发
河南郑州
在线询价

厂家螯合微量元素 螯合钙 螯合铁 螯合铜 螯合镁 螯和锰现货批发
山东临沂
在线询价

厂家批发肥水剂 氨基酸叶面肥水剂水溶肥料 微生物菌剂复合菌
山东潍坊
在线询价

果树有机肥 生物菌肥 改良土壤 生长促根 防病抗逆 提质增收
广西南宁
在线询价

腐殖酸 钾 直销价格 新疆 山东 海南 量大优惠 促根壮棵解磷解钾
广西南宁
在线询价

农用硫酸镁颗粒肥料 山东山旺硫酸镁颗粒 山东厂家硫酸镁颗粒肥料
山东滨州
在线询价

海南龙眼专用冲施肥生根壮棵膨大增甜20kg桶装液体肥鱼蛋白水溶肥
山东济宁
在线询价

厂家批发果树用有机肥 蔬菜用有机肥 广西有机肥厂家批发供应
广西南宁
在线询价

中微量元素水溶肥颗粒全水溶型调节土壤生根壮苗提高产量冲施肥
山东潍坊
在线询价
米力琪 解淀粉芽孢杆菌 活菌200亿纯菌种 抑制病原菌 防病害
山东济宁
在线询价
查看更多产品及报价
100+生物肥料相关产品等你解锁
在线寻源3000行家正在找货
免费询价,源头正品,上1688工业品,全国的工业正品交易平台





